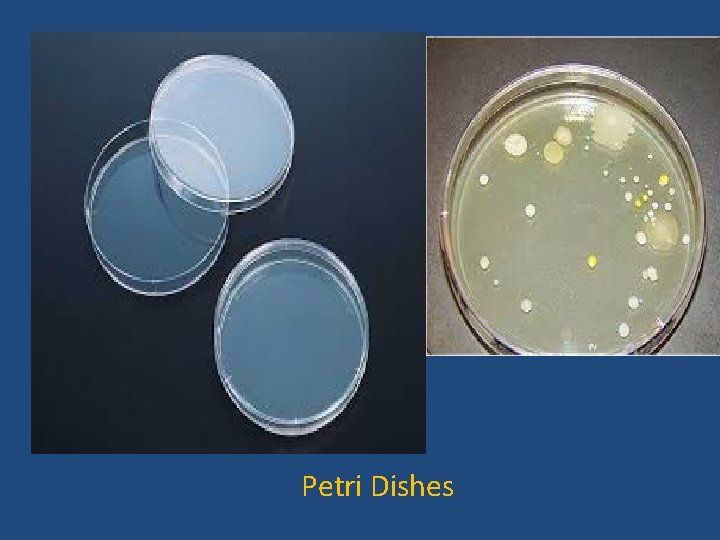
Petri Dishes

Measurement Units of Measurement International System of Units

- Slides: 45
Measurement
Units of Measurement • International System of Units (Metric System) *Used by scientists and just about everyone else in the world (except U. S. A. , Liberia, and Myanmar). * • Units vary by powers of 10 • Prefixes plus base units make up the metric system – Example: • Centi- + meter = Centimeter • Kilo- + liter = Kiloliter • Metric Base Units: – Meter for Length – Liter for Volume – Kilogram for Mass – Degree Celsius for Temperature
Length METER (m) • 1 m = 3. 28 ft • For small distances: – 1 meter (m) = 100 centimeters (cm) – 1 meter (m) = 1000 millimeters (mm) • 1000 meters = 1 kilometer (km)
Mass KILOGRAM (Kg) • 454. 54 g = 1 pound; 1 kg = 2. 2 pounds • 1 Kg = 1000 grams; Grams are used for small objects • Mass is the amount of matter something contains and imparts inertia to an object. • Weight is a measurement of the pull of gravity on an object (it’s a force).
Volume LITER (L) • 1 gallon = 3. 8 liters • 1 L = 1000 milliliters (m. L); milliliters are used for small amounts of liquid • So 1 L is about ¼ of a gallon (about 1 quart) • 1 m. L is about 20 drops of water or 1 sugar cube
Volume • Volume is the amount of space enclosed by an object • Calculated by multiplying L x W x H • 1 liter (L) is the volume of a cube 1 dm (10 cm) on a side • So 1 L = 10 cm X 10 cm • 1 L = 1000 cm 3 • 1 m. L = 1 cm 3
Link between length, mass, and volume • 1 cubic cm (cm 3)… • = 1 g of pure water • = 1 m. L
Now we need to learn prefixes… (They work the same for all metric units!)
Metric Conversion Died By Drinking Chocolate Milk King Henry Kilo Hecto Deka Base Unit Deci Centi Milli 10 x LARGER than a unit 10 x LARGER than a unit Meter Liter Gram 10 x SMALLER than a unit 10 x SMALLER than a unit 1 kilo = 1, 000 units 1 hecto = 100 units 1 deka = 10 units 1 unit 1 deci = 1/10 or 0. 1 unit 1 centi = 1/100 or 0. 01 unit 1 milli = 1/1000 or 0. 001 unit km = kilometer kg = kilogram k. L = kiloliter hm = hectometer hg = hectogram h. L = hectoliter Dkm = dekamater Dkg = dekagram dk. L = dekaliter m = meter g = gram L = liter dm = decimeter dg = decigram d. L = deciliter cm = centimeter cg = centigram c. L = centiliter mm = millimeter mg = milligram m. L = milliliter 5 kilo 50 hecto 500 deca 5, 000 units 50, 000 deci 500, 000 centi 5, 000 milli LARGE TO SMALL UNITS MOVE DECIMAL TO THE RIGHT SMALL TO LARGE UNITS MOVE DECIMAL TO THE LEFT
Move the Decimal Point… • 5. 02 m = 502. 0 cm = 5, 020. 0 mm large unit small unit (large #) • 0. 837 m. L = 0. 000837 L small unit large unit (small #)
Rule of Thumb… • Large unit small unit = LARGE number • Small unit large unit = SMALL number
Common Metric Prefixes Kilo- = Unit X 1000; Kilometer (km) Hecto- = unit X 100; Hectometer (dm) Deka- = unit X 10; Dekameter (hm) Deci- = unit / 10; Decimeter (dm) Centi- = unit / 100; Centimeter (cm) Milli- = unit / 1, 000; Millimeter (mm) Micro- = unit / 1, 000; Micrometer (µm) Nano- = unit / 1, 000, 000; Nanometer (nm)
Be aware that there actually MANY more…
• Convert 1. 7 km to cm. • 1. 7 km = ? m – Multiply by 1000 or move the decimal point to the right three places • 1. 7 km = 1700 m • 1700 m = ? cm – Multiply by 100 or move the decimal point to the right two places • 1700 m = 170, 000 cm • So, 1. 7 km = 170, 000 cm
• Convert 17 mm to meters. – 17 mm = ? cm – Divide by 10 to convert to centimeters or move the decimal point one place to the left. • 17 mm = 1. 7 cm – 1. 7 cm = ? m • Divide by 100 to convert to meters or move the decimal point two places to the left. • 1. 7 cm = 0. 017 m • So, 17 mm = 0. 017 m
• Convert 1. 7 m. L to L – Move the decimal point three places to the left. – 1. 7 m. L = 0. 0017 L
The current standard kg is the International Prototype Kilogram; composed of a platinum-iridium alloy (six copies distributed worldwide) Sphere composed of Silicon-28 likely to become new standard. Why do you think this would be a preferable alternative? Dr. R. M. Moody
World’s Roundest Object http: //www. youtube. com/watch? v= ZMBy. I 4 s-D-Y
Temperature • Temperature: Degrees Celsius – Fahrenheit (F) to Celsius (C) Conversion: • Degrees C = (Degrees F – 32) X 5/9 • Degrees F = (Degrees C X 9/5) + 32 • Boiling and freezing points – Fahrenheit: Boiling = 212⁰ F; Freezing = 32⁰ F – Celsius: Boiling = 100 ⁰ C; Freezing = 0⁰ C Dr. R. M. Moody
Temperature • The standard unit of temperature in the metric system is Kelvin (K) • At 0 K, also known as absolute zero, molecules do not vibrate • You can figure out the temperature in Kelvin by adding: Celsius + 273 Dr. R. M. Moody
• 50⁰C = ⁰F – Multiply 50 by 9/5 and add 32. • 50⁰C =122⁰F • 98. 6 ⁰F = ⁰C – Subtract 32 and multiply by 5/9. • 98. 6 ⁰F = 37 ⁰C
Density • How heavy something is for its size • In other words, density is the ratio between mass and volume for a substance: D=M/V • Density is independent of how much of a substance you have • Mercury and lead have high densities • Air has a low density
D=M/V Density • The formula tells you the units • Units will be in g/m. L or g/cm 3 Example: A piece of wood has a mass of 11. 2 g and a volume of 23 m. L. What is its density?
Comparing Densities • Which object is the most dense? • Which object is the least dense? copyright cmassengale
Tools
Common Apparatuses used to measure Length Meter Stick Metric Ruler
Common Apparatuses used to measure Length Tape Measure
Common Apparatuses used to measure Volume Beakers
Common Apparatuses used to measure Volume Erlenmeyer Flasks
Common Apparatuses used to measure Volume Graduated cylinders
Common Apparatuses used to measure Volume Pipet
Common Apparatuses used to measure Volume Micropipette
Common Apparatuses used to measure Volumetric Buret
Common Apparatuses used to measure Mass
Common Apparatuses used to measure Mass Analytical Balance
Measuring Temperature: Thermometers
Test Tubes and Test-Tube Rack
Petri Dishes
Slides and Coverslips
Dissection Tray Dissection Kit
• Activity: Sketch a beaker, flask, and graduated cylinder. • Activity: Practice using the pipet. • Activity: Practice using the Triple Beam Balance
Accuracy and Precision • Accuracy: Closeness of measurements to the correct or accepted value • Precision: Closeness of a set of measurements of the same quantity made in the same way. – If you measured something over and over again, how close would the values be to one another?
Accuracy and Precision • Let’s say you were shooting at a target. Draw a target with bullet holes that represents each of the following: 1. Precise and accurate 2. Precise and inaccurate 3. Imprecise and accurate 4. Imprecise and inaccurate
Accuracy and Precision